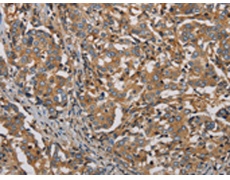
一抗

中文名稱: 兔抗PLIN3多克隆抗體
英文名稱: Anti-PLIN3 rabbit polyclonal antibody
別 名: PP17; TIP47; M6PRBP1
相關類別: 一抗
儲 存: 冷凍(-20℃)
宿 主: Rabbit
抗 原: PLIN3
反應種屬: Human
標 記 物: Unconjugate
克隆類型: rabbit polyclonal
技術規(guī)格
|
Background: |
Mannose 6-phophate receptors (MPRs) deliver lysosomal hydrolase from the Golgi to endosomes and then return to the Golgi complex. The protein encoded by this gene interacts with the cytoplasmic domains of both cation-independent and cation-dependent MPRs, and is required for endosome-to-Golgi transport. This protein also binds directly to the GTPase RAB9 (RAB9A), a member of the RAS oncogene family. The interaction with RAB9 has been shown to increase the affinity of this protein for its cargo. Multiple transcript variants encoding different isoforms have been found for this gene. |
|
Applications: |
ELISA, IHC |
|
Name of antibody: |
PLIN3 |
|
Immunogen: |
Synthetic peptide of human PLIN3 |
|
Full name: |
perilipin 3 |
|
Synonyms: |
PP17; TIP47; M6PRBP1 |
|
SwissProt: |
O60664 |
|
ELISA Recommended dilution: |
2000-5000 |
|
IHC positive control: |
Human liver cancer and Human brain |
|
IHC Recommend dilution: |
50-200 |

 購物車
購物車 幫助
幫助
 021-54845833/15800441009
021-54845833/15800441009